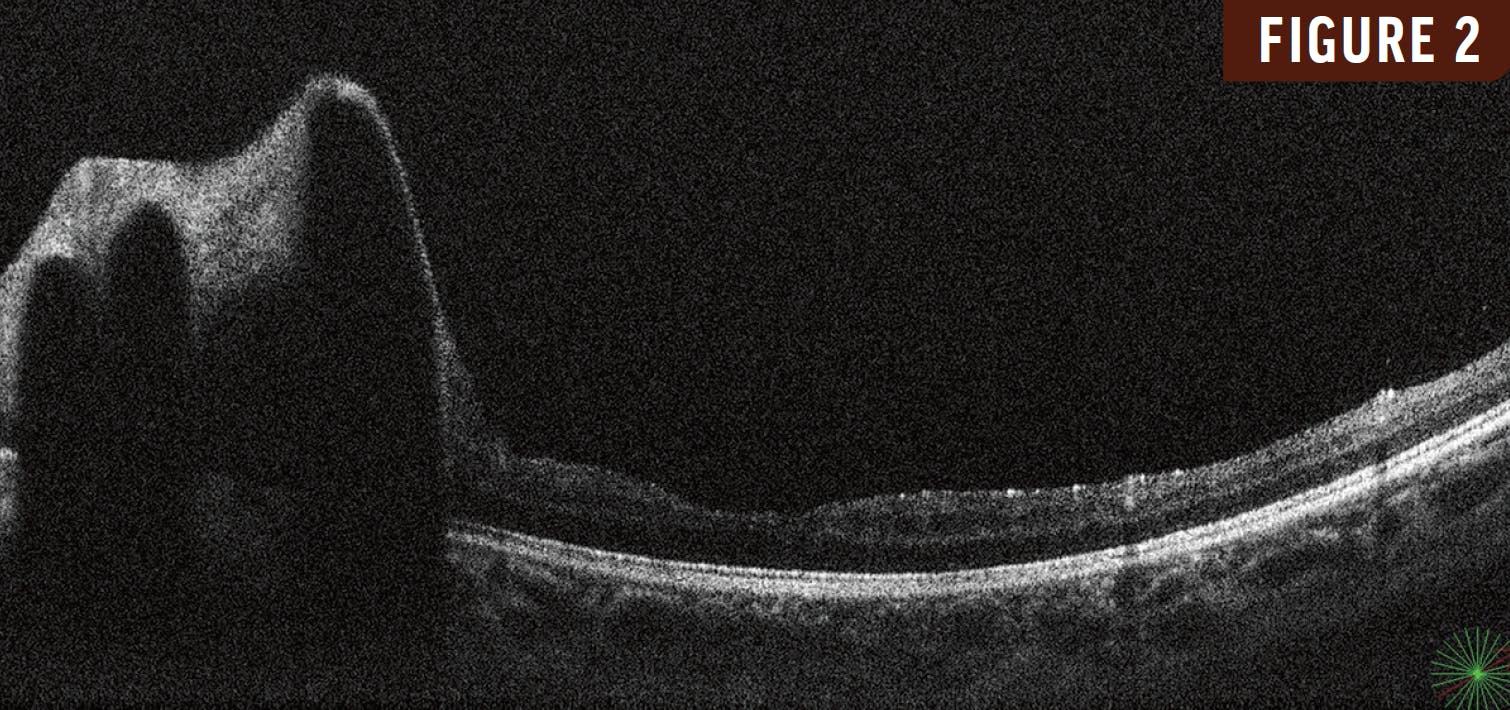

KEY TAKEAWAYS
- Racemose hemangioma is a congenital retinal arteriovenous malformation characterized by dilated tortuous vessels with arteriovenous shunting without intervening capillary bed.
- Although this condition typically remains stable, rare complications may occur, such as hemorrhage, edema, or occlusions.
- Observation with annual follow-up was advised in this case.
A 10-year-old girl presented with a 3-month history of reduced vision in her left eye. Her VA was 20/20 OD and 20/200 OS. Fundus examination of her left eye revealed markedly dilated, corkscrew-like arteriovenous channels with perivascular sheathing that extended from the optic disc into the superotemporal retina (Figure 1). OCT revealed large hyperreflective intraretinal vessels with posterior shadowing and a normal foveal contour (Figure 2). Fluorescein angiography revealed rapid filling of the arterial and venous components with minimal transit time with no associated leakage (Figure 3).
Based on these findings, the patient was diagnosed with racemose hemangioma in her left eye. Neuroimaging to rule out Wyburn Mason syndrome was negative.
WHAT IS RACEMOSE HEMANGIOMA?
Racemose hemangioma is a congenital retinal arteriovenous malformation characterized by dilated tortuous vessels with arteriovenous shunting without intervening capillary bed. These cases typically present unilaterally and, generally, remain stable. Rare complications may occur, however, including hemorrhage, edema, or occlusions.
The child’s parents were counseled regarding the condition, and observation with annual follow-up was advised.

_1773249222.png?auto=compress,format&w=70)

















